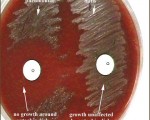

Featured Articles
 11 years ago
11 years agoWhite blood cells: Description, Classification and Formation
 11 years ago
11 years agoBlood Cells and Platelets
 11 years ago
11 years agoGram stain of wound specimen
All Stories

RBCs Agglutination
Agglutination is due to presence of antibodies reacting with antigens on RBCs.
It appear as irregular clumps of red cells. Found in auto immune haemolysis, blood transfusion reaction.

Prealbumin (PAB)
Prealbumin is a plasma protein synthesized by the liver. It is considered the best marker for malnutrition. It has a half-life of 2 days, so prealbumin levels change very quickly and ...

Granular starch
Granular starch is used as powder on surgical and exam gloves. These granules are commonly encountered as contaminants not only in urine sediments, but also in cytology smears of various ...

artifact in wet mount stool examination
on the Left , an amoebic trophozoite.
Right, a squamous epithelial cell with angular appearance, resulting from desquamation of the anal epithelium.
Note in these two cells the different ...

waxy casts in urine
Waxy casts have a smooth consistency but are more refractile and therefore easier to see in a regular wet sediment preparation of urine compared to hyaline casts.
They commonly have ...
Streptococcus-Optochin Sensitivity Testing
Optochin (ethylhydrocupreine hydrochloride), a quinine derivative, has a detergent-like action and causes selective lysis of pneumococci.
A sterile disk impregnated with optochin ...

Gram staining
Gram staining is a method of differentiating bacterial species into two large groups (gram-positive and gram-negative).
Gram staining differentiates bacteria by the chemical ...

Hereditary Pelger-Huët anomaly and Pseudo-Pelger-Huët
Pelger-Huët anomaly is a benign hereditary condition where the majority of the neutrophils possess bilobed nuclei and The cells appear to function normally.
Pseudo-Pelger-Huët ...

Elliptocytes
Elliptocytes are also called pencil cells, cigar cells, and ovalocytes. They are elongated and rod-shaped, often with a central area of biconcavity and pallor, with hemoglobin ...

Schistosoma japonicum eggs
The eggs of Schistosoma japonicum are large and more rounded than other species, measuring 70-100 µm long by 55-64 µm wide. The spine on S. japonicum eggs is smaller and less conspicuous ...

Antigliadin Antibodies [AGA]
Gliadin is part of the gluten protein found in wheat. Gliadin antibodies, also known as antigliadin antibodies (AGA) form in some individuals who are exposed to gluten over a period ...

